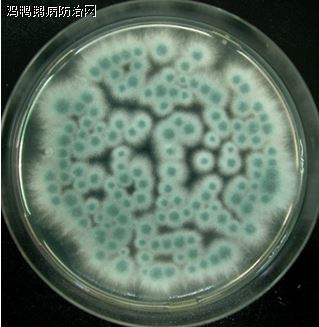

鸡鸭鹅病防治网联合驰骋中兽医研究所共同分享:
以下文章来源于Poultry Times ,作者孔大神
37°C在SDA培养基上的曲霉菌
02. 霉菌的来源
随着种蛋从农场带入
通过空调系统随着空气进入
进入孵化场的物料
使用前未消毒的鸡盒是霉菌的重要污染源
图中的小颗粒就是可浮在空气中的霉菌孢子
如何空气采样?
黄曲霉 Aspergillus flavus
烟曲霉 Aspergillus fumigatus
黑曲霉 Aspergillus niger
严重的雏鸡霉菌肺炎(来自Merck Vet Manuel)
出现霉菌肺炎症状的雏鸡
另外也可液体形式的可以配合冲洗消毒使用。
霉菌问题,也可能来自农场。
尤其是蛋内霉菌的问题,这是孵化场无论做什么都收效甚微的。
注:鸡鸭鹅病防治网、白羽肉鸡信息产业库经授权发布,转载请联系作者。
无抗养殖首选解决2问题:肠道病(病从口入) 霉菌病、真菌病 等净化传染病的消毒模式:
1、改善水质、净化养殖环境:用驰骋一片净,每周三定期消毒一次,即可达到净化养殖环境目的(祛除棚舍氨气、空气净化首选--驰骋一片净(减少呼吸道疾病传播))。经过数百家养殖企业使用证明:选用驰骋一片净,消毒效果好!对多种病毒、细菌、真菌有效率达93%-98.5%。畜禽养殖防控肠道病好用、有效、实惠、方便、便宜等特点的产品--驰骋一片净(10000只鸡1天只需25-30元的药费即可解决病从口入)老养殖朋友都在用,您还在等什么............
2、杀灭真菌霉菌孢子、清除场地霉菌滋生:用驰骋克真霉,每15-20天定期饮水消毒3天,即可杀灭畜禽体内霉菌孢子、真菌孢子的生长;杀灭场地霉菌孢子的方法,建议每周至少在畜禽生长、活动的场地内喷雾消毒一次。
3、杀毒灭菌、抗炎消炎:用驰骋碘无忧泡腾片就对了✔饮用给药效果好!1片兑水50公斤,精准用药,预防蛋禽输卵管炎、卵巢炎首选驰骋碘无忧。可有效杀灭病毒(口蹄疫、非洲猪瘟、禽流感、副黏病毒、黄病毒、腺病毒等)、细菌(大肠杆菌、沙门氏菌、禽霍乱、鸭疫巴氏杆菌、葡萄球菌、链球菌等)、支原体等病原体!效果确切!事实胜于雄辩。喷雾消毒、饮水消毒、环境消毒、棚舍消毒、料槽消毒等消毒就用驰骋碘无忧,好用!
鸡鸭鹅病防治网为规模化养殖企业(场)提供疫病防控最佳解决方案!!!
禽病实战专家咨询:13939028068 (技术总监-魏老师 个人 微信:CC-zbs 欢迎交流)博客http://blog.sina.com.cn/u/3862264327
养殖安、驰骋钙、新力爽等产品销售顾问:成龙在路上 13838248089 博客:http://blog.sina.com.cn/gallopschenglong
来源:鸡鸭鹅病防治网 分享 http://www.jyebfz.com 中兽医 http://www.中兽医.com
Rodac接触平皿很适合在孵化场采样

发表评论共有0访客发表了评论
暂无评论,快来抢沙发吧!